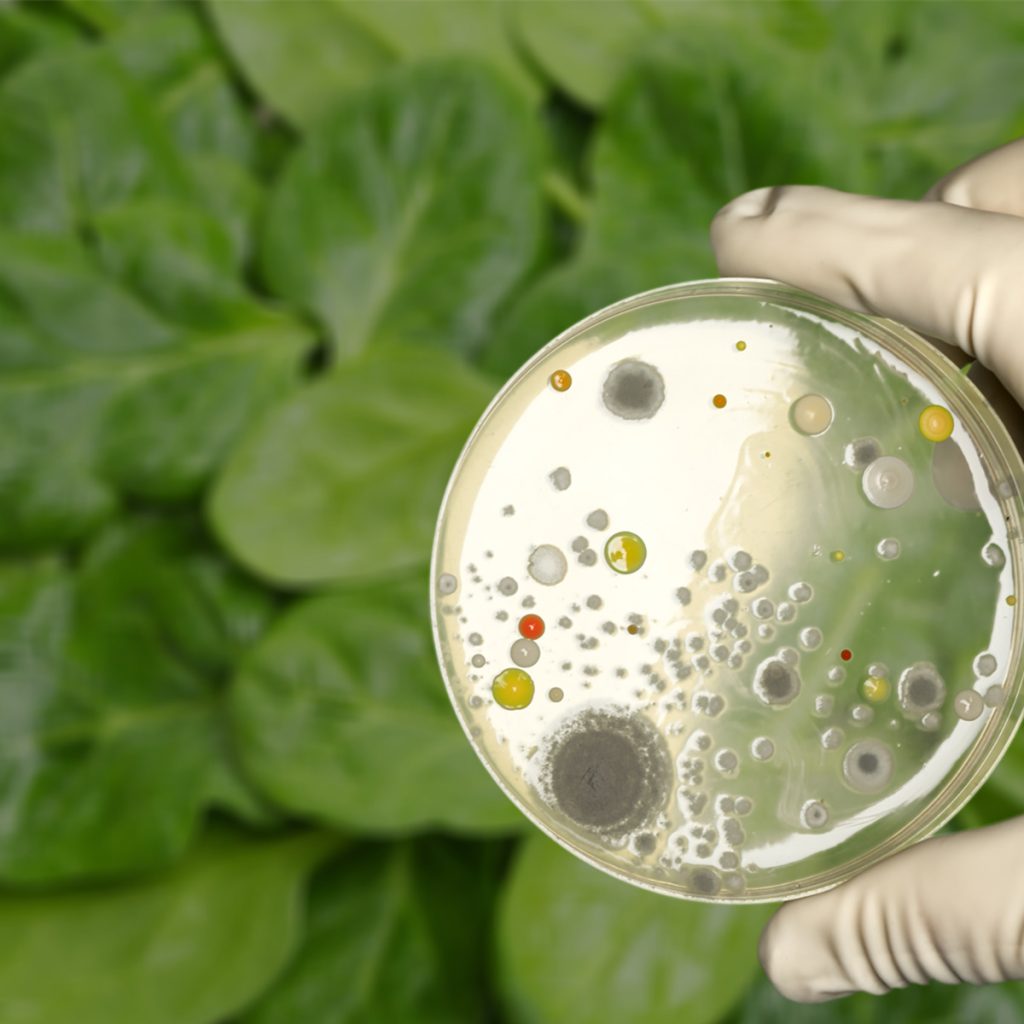

โพสต์ลง 12 ธันวาคม 2568 โดย คีนน์
การทำความสะอาดผัก ผลไม้

ผักและผลไม้ถือเป็นหนึ่งในวัตถุดิบเบื้องต้นในกระบวนการประกอบ หรือผลิตอาหาร มีมาตรฐานในการควบคุมหลายข้อตั้งแต่ต้นทางของการปลูก เก็บเกี่ยวภายใต้การปฏิบัติ อาทิเช่น การควบคุมการใช้ปุ๋ย หรือยาฆ่าแมลงสะสม วิธีการเก็บ การทำความสะอาด มาจนถึงการแปรรูปภายใต้มาตรฐานการผลิตอาหาร HACCP หรือ GMP
อย่างไรก็ดีไม่อาจสรุปได้ว่า เรามีขั้นตอนการฆ่าเชื้อโรคในผัก ผลไม้ โดยเฉพาะยาฆ่าแมลงได้ทั้งหมด เพราะการปนเปื้อนสามารถเกิดได้ในทุกส่วนของกระบวนการ การสัมผัส การขนส่ง การทำความสะอาดตัดแต่ง นำพาการปนเปื้อนเหล่านั้นสู่กระบวนการผลิต และการส่งออก อาจสร้างความเสียหายต่อผู้ประกอบการทั้งการตรวจพบเจอสารตกค้างก่อนส่งออก ปัญหาเรื่องสุขอนามัยอาหารต่อผู้บริโภค สร้างความยุ่งยากในการจัดการอาหารที่ปลายทางเสมอ
ความเสี่ยงจากเชื้อโรคและยาฆ่าแมลงตกค้าง
การใช้ผักผลไม้ที่มีสารตกค้างหรือเชื้อโรคสามารถก่อให้เกิดปัญหาสุขภาพต่อผู้บริโภคและเพิ่มต้นทุนการผลิต
เชื้อโรคที่พบบ่อย
- Salmonella
- Staphylococcus
ยาฆ่าแมลงตกค้างที่พบบ่อยในผักผลไม้
- Carbofuran: กำจัดหนอนและแมลง
- Methomyl: กำจัดแมลงหลายประเภท
- Dicrotophos: กำจัดแมลงปากดูดและกัด
- EPN: ใช้เป็นหัวยาผสมสารเคมี
-

BLOG2025-28_Cleaning-Vegetables-02
-
BLOG2025-28_Cleaning-Vegetables-03
-

BLOG2025-28_Cleaning-Vegetables-04
ทำไมจึงควรหลีกเลี่ยงการใช้เคมีในการฆ่าเชื้อโรคและจุลินทรีย์กับผัก ผลไม้ในการผลิต
- การตกค้างของสารเคมี จากการล้างออกได้ไม่ดีพอ
- การใช้ที่มากเกินกว่าที่กำหนด อาจก่อให้เกิดสารพิษที่เป็นอ้นตราย
- การระคายเคือง จากการสัมผัสที่ส่งผลต่อผิวหนังและดวงตา โดยเฉพาะผู้ปฏิบัติงานที่มีปัญหาแพ้ง่าย ผิวหนังบอบบาง
- การสูดดมสารระเหย อาจส่งผลระคายเคืองต่อทางเดินหายใจ
- การใช้สารเคมี อาจทำลายวิตามิน และสารอาหารบางอย่างในผักและผลไม้ อาจทำให้คุณค่าทางโภชนาการลดลง
- ผลกระทบต่อสิ่งแวดล้อม จากการปล่อยน้ำสู่แหล่งน้ำธรรมชาติ เนื่องจากมีสารพิษต่อสัตว์น้ำและสิ่งมีชีวิตในน้ำ
การเลือกใช้ วิธีทำความสะอาดผักผลไม้ที่ปลอดภัยและมีประสิทธิภาพ ช่วยให้ทั้งผู้ผลิตและผู้บริโภคมั่นใจ ในความปลอดภัยอาหาร ลดการสะสมของเชื้อโรคและยาฆ่าแมลง พร้อมยืดอายุและลดต้นทุนการผลิต การใช้นวัตกรรมซูเปอร์ออกไซด์อิออน หนึ่งในนวัตกรรมผสานระหว่าง Hydrogen Peroxide และ Acetic Acid ทำให้เกิดประสิทธิภาพสูงต่อการสลายอนุภาค ลดการสะสมของเชื้อโรคหลายชนิดได้ในเวลาอันรวดเร็ว เป็นอีกทางเลือกหนึ่งที่เหมาะสมสำหรับอุตสาหกรรมอาหารยุคใหม่




